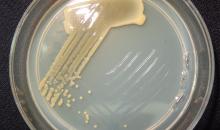

Clavibacter insidiosus(CORBIN)
Photos
All photos included on this page can only be used for educational purposes.
For publication in journals, books or magazines, permission should be obtained from the original photographers with a copy to EPPO.
For publication in journals, books or magazines, permission should be obtained from the original photographers with a copy to EPPO.
Morphology and colony characteristics of Clavibacter insidiosus strain CFBP 2404 on YPGA medium.
Courtesy: Ebrahim Osdaghi
Discoloured stele (left) and pockets of infection on inner surface of bark (right) of lucerne infected by C. michiganensis subsp. insidiosus.
Courtesy: APS, St Paul (US).

